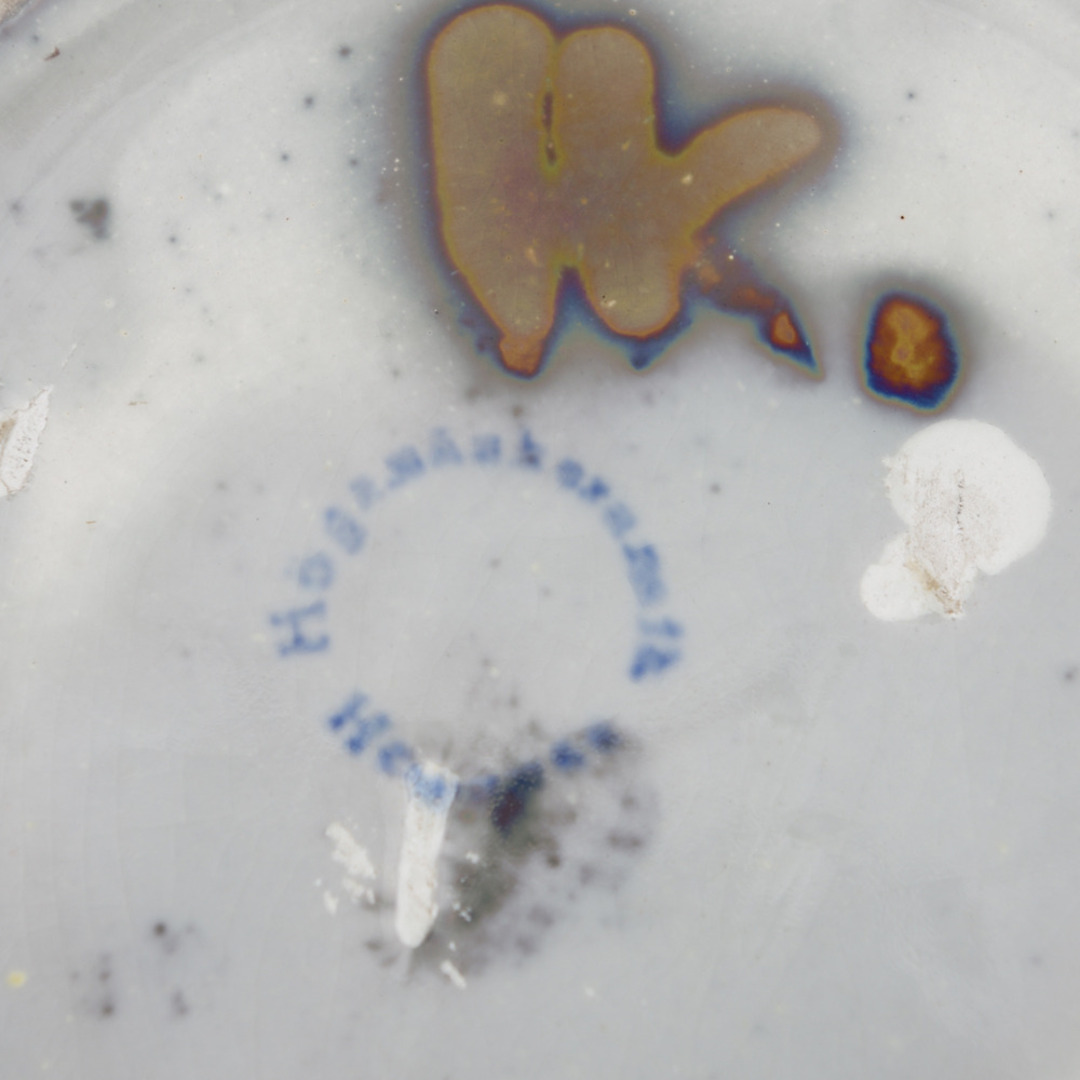

Her er de forskellige typer cookies, der benyttes på Auctionet.com, samt en beskrivelse af, hvad de gør. Du kan selv vælge, hvilke typer cookies du giver dit samtykke til.
Du kan læse mere i vores integritetspolitik.
Altid aktive
Disse cookies er nødvendige for, at Auctionet skal fungere korrekt.
Auctionet gemmer informationer for at kunne identificere dig under dit besøg. De bruges blandt andet til at holde dig indlogget.
Auctionet gemmer dine aktuelle cookieindstillinger
Cookies, der bruges til at tilpasse indhold og funktioner på Auctionet.
Auctionet gemmer din besøgshistorik, så du nemt kan finde tilbage til genstande, du har besøgt.
Auctionet gemmer information om, hvilket sprog og hvilken valuta der skal benyttes.
Disse cookies anvendes til at udvikle og forbedre Auctionet ved at indsamle statistik.
Auctionet analyser brugeradfærd for at kunne forbedre tjenesten.
Auctionet tester regelmæssigt nye funktioner og forbedringer.
Disse cookies bruges til at vise relevant indhold på andre websites.
Auctionet analyserer, hvordan du bruger tjenesten for at kunne give dig tips om relevant indhold på andre websites.